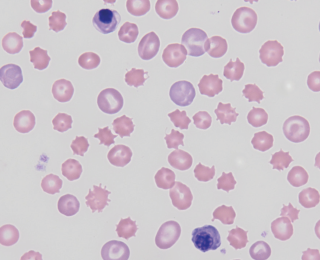
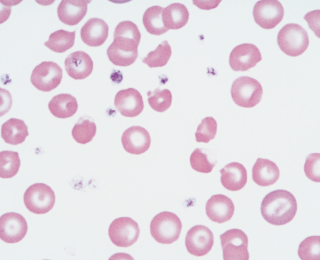
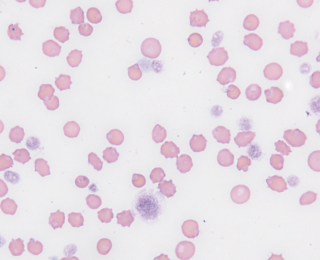
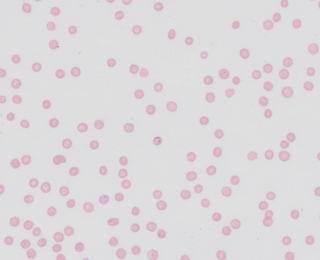
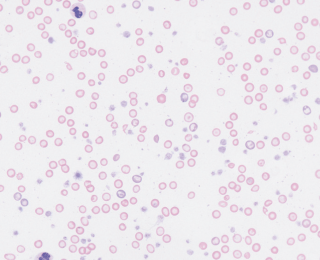
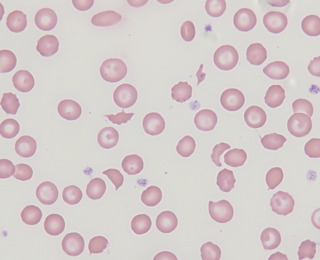
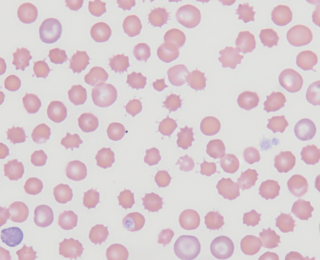
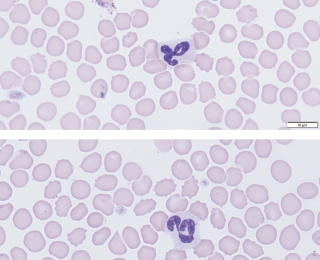
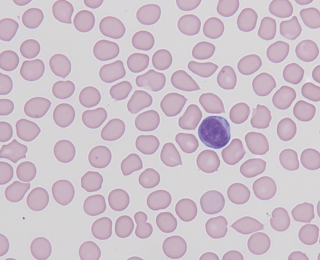
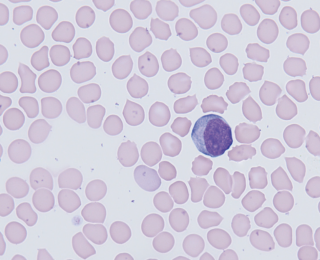
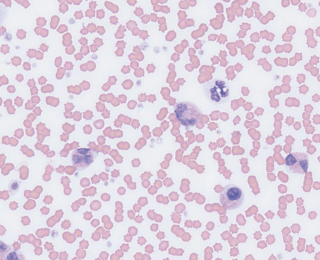

Small animal - February 2020
Emergency cytology I: blood smear assessment
Interpreting cytology in-house is an incredibly useful skill to have when dealing with emergency patients. Often the ongoing diagnostic and treatment plans hinge on these results and timely assessment can make a big difference to patient management. In a two-part series, Poppy Gant BVSc MRCVS will provide a quick guide to the use of cytology in emergency patients. Part one, in this issue, will focus on blood smear assessment, including preparation, examination and the basic assessment of red blood cells, white blood cells and platelets
Interpretation of a blood smear cannot be performed without first appropriately preparing and staining a blood smear. Failure, at this stage, can make interpretation difficult or even result in drawing inappropriate conclusions that could, ultimately, affect patient management.
How to make a blood smear
- Use room-temperature, well-mixed, clot-free EDTA sample.
- Use a microhaematocrit tube to place a small dot of blood at the base of a slide.
- Hold the spreader slide at a 30-45o angle.
- Back into the drop of blood and as soon as the drop spreads along the edge, push forward in a smooth, reasonably fast motion.
- Apply gentle pressure to just keep the spreader slide on the glass.
- Allow slide to air dry.
- Stain with rapid commercial Romanowsky stain (eg. DiffQuik or equivalent). Generally, 10-15 ‘agitations’ in each solution, blotting in between, then rinsing with distilled water and again allowing to air dry).
The classic blood smear has a 'thumb print' appearance with:
- A well-developed feathered edge;
- The dense body of the smear taking up most of the slide; and
- A thin monolayer which blends the feathered edge and the dense body. This is generally defined under the microscope as the area in which 50% of red blood cells are touching without overlapping.
Common pitfalls in making blood smears
- Too much blood on slide.
- Spreader slide angle too shallow – if smear is too ‘long’ (especially in anaemic patients) then increase spreader slide angle.
- Incorrect staining – over or under staining will make assessment of red blood cell regeneration difficult.
- Debris accumulation in stains. This can often be mistaken for bacteria.
How to quickly assess the key aspects of a blood smear
- Scan over the whole smear at low power to ensure diagnostic.
- Assess the feathered edge of the smear at x10 for platelet clumps (this will falsely decrease the platelet count).
- Assess the monolayer at x30-100 for red and white blood cell morphology (+/- differential count).
- Platelet count:
- Using the 100x magnification with oil immersion, count the number of platelets per high power field in the monolayer. You can also assess for macroplatelets;
- Repeat over 10 fields to calculate an average platelet count; and
- Multiply the average (P) by 15 to estimate the platelet count: (Px15) x10^9/L.
Basic questions that a brief assessment of a blood smear can try to help answer
- Is an anaemia regenerative or non-regenerative?
- Are the any red blood cell morphology changes?
- Determine/confirm changes in the white blood cell differential count.
- Assess neutrophils for left shift and toxic changes.
- Determine platelet count.
Assessment of anaemia
Evaluating the bone marrow response to a low red blood cell count, along with history and physical examination, is the first step in characterising an anaemia. Figure 3 gives an abbreviated schematic for the initial assessment of anaemia.Figure 3: Abbreviated differential flow chart of anaemia.
Regenerative or non-regenerative?
Red blood cells are produced from haematopoietic stem cells in the bone marrow. More immature cells have larger amounts of ribonucleic acid (RNA) for protein (eg. haemoglobin) synthesis.
Rubriblasts Nucleated red blood cells (metarubricytes)
Reticulocytes Mature red blood cells
Reticulocytes normally stay in the bone marrow for approximately 24 hours before being released to finish their final maturation in circulation. With requirement for accelerated regeneration, increased reticulocytes, or even nucleated red blood cells, can be released. Rubriblasts are typically only seen with pathology such as leukaemias.
Reticulocytes can be further classified as aggregate and punctate. Aggregate reticulocytes contain larger amounts of RNA and therefore stain ‘blue’ with ‘DiffQuik’ or similar. These are then called ‘polychromatophils’. Punctate reticulocytes do not stain blue but may still be larger than mature red blood cells (and are then called ‘macrocytes’).
The degree of polychromasia can therefore be used to assess and subjectively quantify the degree of regeneration (eg. mild, moderate or marked). In dogs, both aggregate and punctate reticulocytes circulate for one to two days and therefore assessing the degree of polychromasia alone will underestimate regeneration. In cats however, polychromasia is a good indicator of active regeneration, as punctate reticulocytes can continue to circulate for seven to 10 days (indicating previous, rather than current regeneration).
Pitfalls: When regenerative anaemias don’t look regenerative
- Pre-regenerative anaemia – particularly if not clear from the history when the animal became unwell.
- Secondary bone marrow suppression due to systemic disease (although with severe anaemias, the overall picture should still be strongly regenerative).
- Haemolysis or haemophagocytosis of early red blood cell maturation stages (eg. erythroid precursors).
- Cats with mild or slowly developing anaemias may lack polychromasia (ie. they may only release punctate reticulocytes).
Other findings that may be associated with a regenerative anaemia
Anisocytosis = increased variation in red blood cell size (diameter).
- This can be due to an increase in larger or smaller red blood cells or a combination of both.
- This is generally associated with a regenerative response but can be seen in some non-regenerative anaemias eg. macrocytosis in cats with feline leukaemia virus.
Nucleated red blood cells (nRBC)
Typically seen in dogs and cats with strongly regenerative anaemias, particularly dogs with immune mediated haemolytic anaemia.
nRBC can closely mimic lymphocytes (especially where the later are ‘reactive’ with increased cytoplasm).
Other differentials include:
Splenic pathology; and
Bone marrow injury, eg. heat stroke.
Haemorrhage or haemolysis?
- If an appropriate degree of regeneration can be seen on a blood smear, then several features may help to indicate the underlying cause.
- If there are no signs consistent with haemorrhage, then additional blood smear characteristics may help to identify the cause of a haemolytic anaemia.
- Spherocytes: develop with partial phagocytosis of erythrocytes in the spleen (extravascular haemolysis). Characteristics include a small diameter, dense staining cell with lack of central pallor. They are typically associated with immune mediated anaemia but can be seen with other pathology.
- Ghost cells: are those which have ruptured and lost their haemoglobin. They develop secondary to intravascular haemolysis (although be aware of artefacts). True in vivo haemolysis will be associated with haemoglobinaemia/haemoglobinuria.
Evidence of oxidative damage
Oxidant injury is supported by the presence of eccentrocytes and heinz bodies:
- Eccentrocytes – ‘hemi-ghost cells’ with an eccentric central pallor; and
Heinz bodies – can be seen on Romanowsky type smears if ‘noses’ are large and distort the RBC membrane. Smaller heinz bodies that may be seen in normal cats may only be detected with special stains. - Both eccentrocytes and heinz bodies can be seen in normal dogs and cats and therefore should be present in large numbers to be considered the primary pathology.
A note on immune-mediated hemolytic anemia
Immune mediated haemolytic anaemia (IMHA) is a continuous spectrum of disease in which the immune system can attack any maturation stage of the red blood cell. The ‘classic’ IMHA involves destruction of the circulating mature RBCs. However, the immune system can also target reticulocytes in circulation and also ‘precursors’ in the bone marrow (which can then result in the appearance of an ‘inappropriate’ or ‘non-regenerative’ anaemia).
Non-regenerative anaemia
Patients are less likely to present acutely for a non-regenerative anaemia, as the body has time to develop adaptive mechanisms to cope with reduced oxygen delivery. However, acute decompensation may be perceived, or an owner may suddenly notice pale mucous membranes. This can initially make it difficult to distinguish whether the problem is acute or chronic, particularly in reclusive indoor cats in which lethargy or exercise intolerance is often missed.
Figure 10 gives an abbreviated schematic for the assessment of a non-regenerative anaemia based on the size and colour of the red blood cells.
In-house cytology is most useful in non-regenerative anaemias to document other cytopenias eg. neutropenia or thrombocytopenia. Documenting these is the most likely finding that will alter the diagnostic and treatment plan.
Another easily appreciable change on cytology is a microcytic, hypochromic anaemia. This is most often seen with iron deficiency anaemia (and should prompt evaluation of chronic, low grade, gastrointestinal haemorrhage). It can also be seen with portosystemic shunts or lead toxicity (the latter of which may also be associated with neutropenia).
Other red blood cell morphology changes
Fragmentation (microangiopathic damage)
Fragmentation can occur secondary to vascular disease (eg. vasculitits or neoplasia of vessels such as haemangiosarcoma) or disseminated intravascular coagulation (DIC). They are typically non-regenerative as the underlying disease often causes some degree of bone marrow suppression. Alone, these are likely to be the sole cause of anaemia, unless seen in particularly high numbers. Characterised by:
- Schistocytes;
- Acanthocytes – irregularly spiculated ‘spur cells’; and
- Keratocytes (non-specific – may also be seen in oxidation injury – in which case would be more likely to see with eccentrocytes and heinz bodies).
Acanthocytes can also be seen in a range of other disorders, including liver disease. However, it is important to differentiate them echinocytes (regularly spiculated ‘burr’ cells) which are commonly artefactual due to aged blood or excess EDTA and therefore are rarely of pathological significance
White blood cells
There are two types of white blood cell:
- Granulocytes = granules in cytoplasm (eg. neutrophils, eosinophils, and basophils); and
- Mononuclear cells = ‘round’ (but not always) nuclei (eg. lymphocytes and monocytes).
It is not uncommon for inhouse analysers to misinterpret the different types of white blood cell and therefore provide an incorrect differential count. Ideally all haematology tests requested should have the differential confirmed manually but particularly when results are unexpected. Sometimes even manual interpretation can be difficult eg. immature neutrophils and monocytes.
Neutrophils
In health, only mature neutrophils are released from the bone marrow to circulate. Mature neutrophils can be very variable in appearance but are generally smaller, have increased nuclei segmentation and less RNA in the cytoplasm (ie. ‘less blue’ on DiffQuik type stains).
A ‘reserve’ neutrophil pool exists in the bone marrow and is released upon increased demand. Where demand is high, immature neutrophils can also be released. This includes bands, metamyelocytes and myelocytes which have round to ‘horse-shaped’ nuclei with no deep indentation (ie. <50% of the nuclei width).
A ‘left shift’ refers to increases in circulating immature neutrophils (usually ‘bands’). This usually indicates a response to inflammatory cytokines (an inflammatory leukogram), although this can also be seen with bone marrow disorders or neoplasia. A ‘degenerate’ left shift means there are more immature than mature neutrophils and this has been associated with a worse prognosis. A left shift neutrophilia is often accompanied by ‘toxic’ changes which represent accelerated neutrophil maturation. A patient with a normal neutrophil count but a left shift or toxic changes should have their neutrophil count closely monitored as this can indicate overwhelming inflammation with risk of neutropenia.
Toxic changes include:
- Basophilic (blue) cytoplasm;
- Cytoplasm vacuolation; and
- Dohle bodies (blue aggregates in cytoplasm).
Neutrophilia is often hard to quantify on a blood smear. In contrast, severe neutropenia can easily be identified (see Figure 11). Some broad causes of neutropenia include:
- Consumption secondary to severe inflammation – especially with left shift and toxic change;
- Decreased production from the bone marrow; and
- Immune mediated destruction – either in the periphery or in the bone marrow.
Lymphocytes
Circulating mature lymphocytes are usually small with a round nuclei and small amounts of light blue or colourless cytoplasm. ‘Reactive’ lymphocytes may also be seen. These can vary in size and usually have an increased amount of dark blue cytoplasm. They represent a non-specific response of the immune system. It is important to differentiate these from nucleated red blood cells. Bone marrow disorders can also result in the release of large ‘lymphoblasts’.
Eosinophils
Eosinophils can have a variable appearance, but their most characteristic appearance is the pink staining granules in their cytoplasm. They are most commonly associated with hypersensitivity reactions and parasite infections, but other important differentials include a paraneoplastic response, idiopathic hypereosinophilic syndromes or rarely leukaemia.
Platelets
Manually confirming a platelet count is an important skill as automated analysers are prone to reporting a pseudothrombocytopenia. This is particularly common in cats which have ‘reactive’ platelets (leading to clumping) and a considerable overlap between erythrocyte and platelet volume.
A normal platelet count is roughly 150-450x109/L. This equates to 10-30 platelets per high power field. It is not uncommon for sick animals to have a mild thrombocytopenia, but evidence of primary haemostatic disease is rarely seen until the platelet count decreases to <20-30x10^9/L. This severe thrombocytopenia is most often seen with primary or secondary immune mediated destruction or DIC.
Summary
With practice, a focussed assessment of a blood smear can be performed within five to 10 minutes. This should, ideally, be performed in all emergency patients, but particularly those with an anaemia or suspected primary haemostatic disease in which it can greatly assist in developing a diagnostic and treatment plan.
References available on request
Sincere thanks go to Dr Laureen Peters DVM MVetMed MRCVS ACVP and Paul Barber (senior haematology technician) for their assistance in providing photomicrographs.
1. Which is the best red blood cell feature for assessing regeneration?
a. Anisocytosis
B. Polychromasia
C. Presence of inclusions
D. Presence of nucleus
2. Which of the following are characteristic of extravascular haemolysis?
a. Ghost cells
B. Spherocytes
C. Heinz bodies
D. Echinocytes
3. Which of the following may be seen if a dog ingests garlic?
a. Heinz bodies
B. Acanthocytes
C. Dohle bodies
D. Schistocytes
4. What does a left shift neutrophilia most likely indicate?
a. Bone marrow pathology
B. Increased endogenous corticosteroids
C. Presence of septicaemia
D. Increased inflammatory cytokines
5. A dog has 2 platelets per high power field. What is the most likely cause?
a. Evan’s syndrome
B. Severe haemorrhage
C. Immune mediated thrombocytopenia
D. Ehrlichia
Answers: 1:B; 2:B; 3:D; 4:A; 5:C.